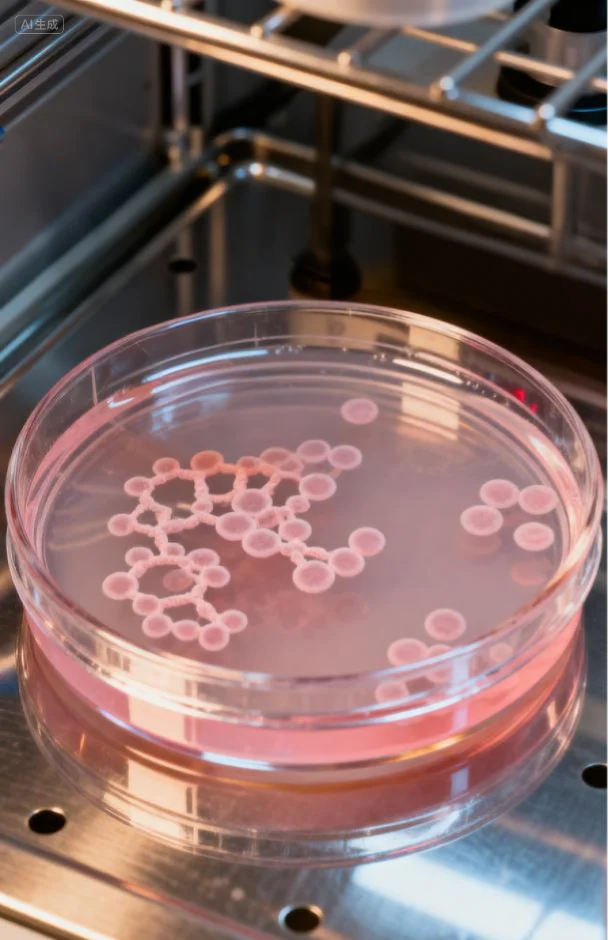

在微生物研究、药物生产、环境监测、高校科研等领域,一台性能稳定、控制精准的生化培养箱是实验成功的重要保障。然而,实验室人员常常面临这样的困扰:
●温度波动大,实验重复性差?
●操作复杂,程序设定不方便?
●观察样品需开门,影响箱内环境?
●密闭空间,制冷散热量大影响其它机器?
●低温高温压缩机卯足劲工作,噪音大、能耗大?
●运行不到1年压缩机、电机等配件老坏?
针对这些痛点,环美生物医疗推出5大系列生化培养箱,以精准控温、智能操控、人性化设计,为您的实验保驾护航!

生化培养箱主要用于细菌、霉菌等微生物的培养、植物育种、种子发芽、样品保存等。其核心价值在于提供一个温度可控、均匀稳定的环境,确保实验条件的一致性,从而保证研究成果的可靠性与准确性。

6大核心特点:(1)温度准确,温度均匀性达±0.8℃(@25℃);(2)双门设计(外门避光,内门可视);(3)全自动化霜检测,减少温度波动。(4)日常维护保养智能提醒功能。(5)企业封闭洁净室不易造成环境升温。(6)使用优质配件,整机2年质保,质量稳定可靠。
适用场景:常规微生物培养、教学演示、样品长期保存。
亮点:操作简单,性价比高,适合预算有限、需求明确的用户。

8大核心特点:除R系列特点外,还有:(7)具备30段程序运行能力;(8)可选配WiFi模块实现远程手机或电脑监控。
适用场景:需要多温度段切换的复杂培养流程。
亮点:在基础款上增加程控功能,灵活性更强,适合科研进阶使用。同时兼容远程控制,监视贵重培养样品状态。

10大核心特点:除RL系列特点外,还有:(9)采用LCD彩屏,视觉更美观;(10)配置独立限温器防止过温安全保护样品。
适用场景:对温度安全要求高、样品数量多的实验室。
亮点:显示更直观,安全防护更全面,空间利用率更高。同时兼容远程控制,监视贵重培养样品状态。

12大核心特点:除RC系列特点外,还有:(11)5寸触摸屏,支持U盘导出运行数据。(12)三级权限管理与数据追溯功能。
适用场景:需要数据追溯、发表论文或GMP合规要求的场景。
亮点:操作便捷,数据管理功能强大,适合高质量科研与合规实验室。

15大核心优势:除RT系列特点外,还有:(13)7寸彩色触摸屏,有曲线显示功能;(14)可配低浓度1000PPM-5000PPM二氧化碳CO₂或氧气O₂控制功能。(15)使用双变频控制即变频压缩机和变频控制,温度更精准,噪音低,更节能。
适用场景:高端科研、大容量恒温培养、需要长期无人值守的项目。
亮点:容积更大(可达475L),功能全面,满足高端实验室需求。
生化培养箱是实验室的核心和通用设备,其关键优势在于:
温度精准稳定
提供恒定的温度环境,确保微生物、细胞等培养结果准确可靠,实验重复性强。
有效防止污染
密闭设计营造洁净空间,避免外界微生物污染,守护样品纯净。
操作简单直观
界面简洁,上手快,能快速投入实验,提升工作效率。
智能自动编程
可预设多段温度程序,自动完成复杂培养流程,省时省力,解放人力。
全面安全保护
具备过温、故障、漏电等多重保护,保障实验安全与设备稳定运行。可远程监控,安全随时掌握在自己手中。

中文
English

